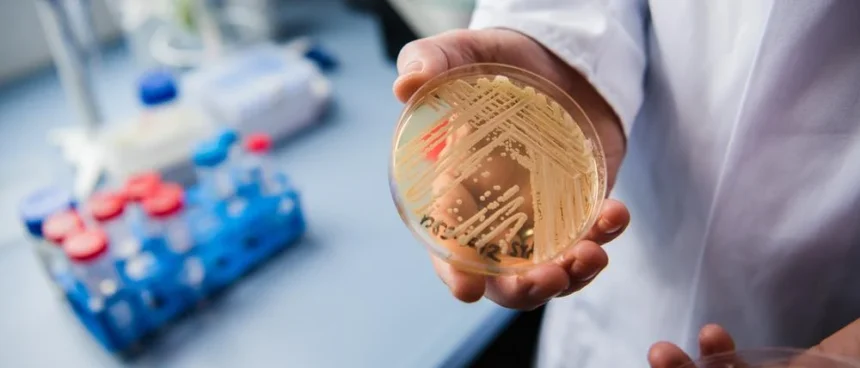
ce este candidozyma auris imuna la multiple medicamente si care se raspandeste in romania 68c2cc85c4854

Despre Candidozyma auris
Ciuperca patogenă Candidozyma auris, cunoscută anterior ca Candida auris, se răspândește rapid în spitalele din Europa. Identificată pentru prima dată în Japonia în 2009, aceasta a fost raportată în cinci țări europene: Spania, Grecia, Italia, România și Germania, care au concentrat majoritatea cazurilor înregistrate în ultimul deceniu.
Rezistența și riscurile asociate
Candidozyma auris este rezistentă la multiple medicamente și poate provoca infecții grave la pacienții vulnerabili. Dificultățile de control sunt amplificate de capacitatea ciupercii de a supraviețui pe diverse suprafețe și dispozitive medicale, precum și de transmiterea prin contact direct.
Creșterea cazurilor în Europa
Între 2013 și 2023, au fost înregistrate peste 4.000 de cazuri în Uniunea Europeană și în Spațiul Economic European, dintre care 1.346 doar în 2023. ECDC subliniază că aceste date reprezintă doar „vârful aisbergului”, multe țări neavând un sistem de raportare eficient pentru aceste infecții.
Măsuri de prevenire
Autoritățile sanitare europene subliniază importanța eforturilor naționale de depistare și monitorizare pentru limitarea răspândirii Candidozyma auris în spitale.
Concluzie
Creșterea alarmantă a cazurilor de Candidozyma auris în Europa subliniază necesitatea unor măsuri rapide și eficiente pentru protejarea pacienților vulnerabili din spitale.